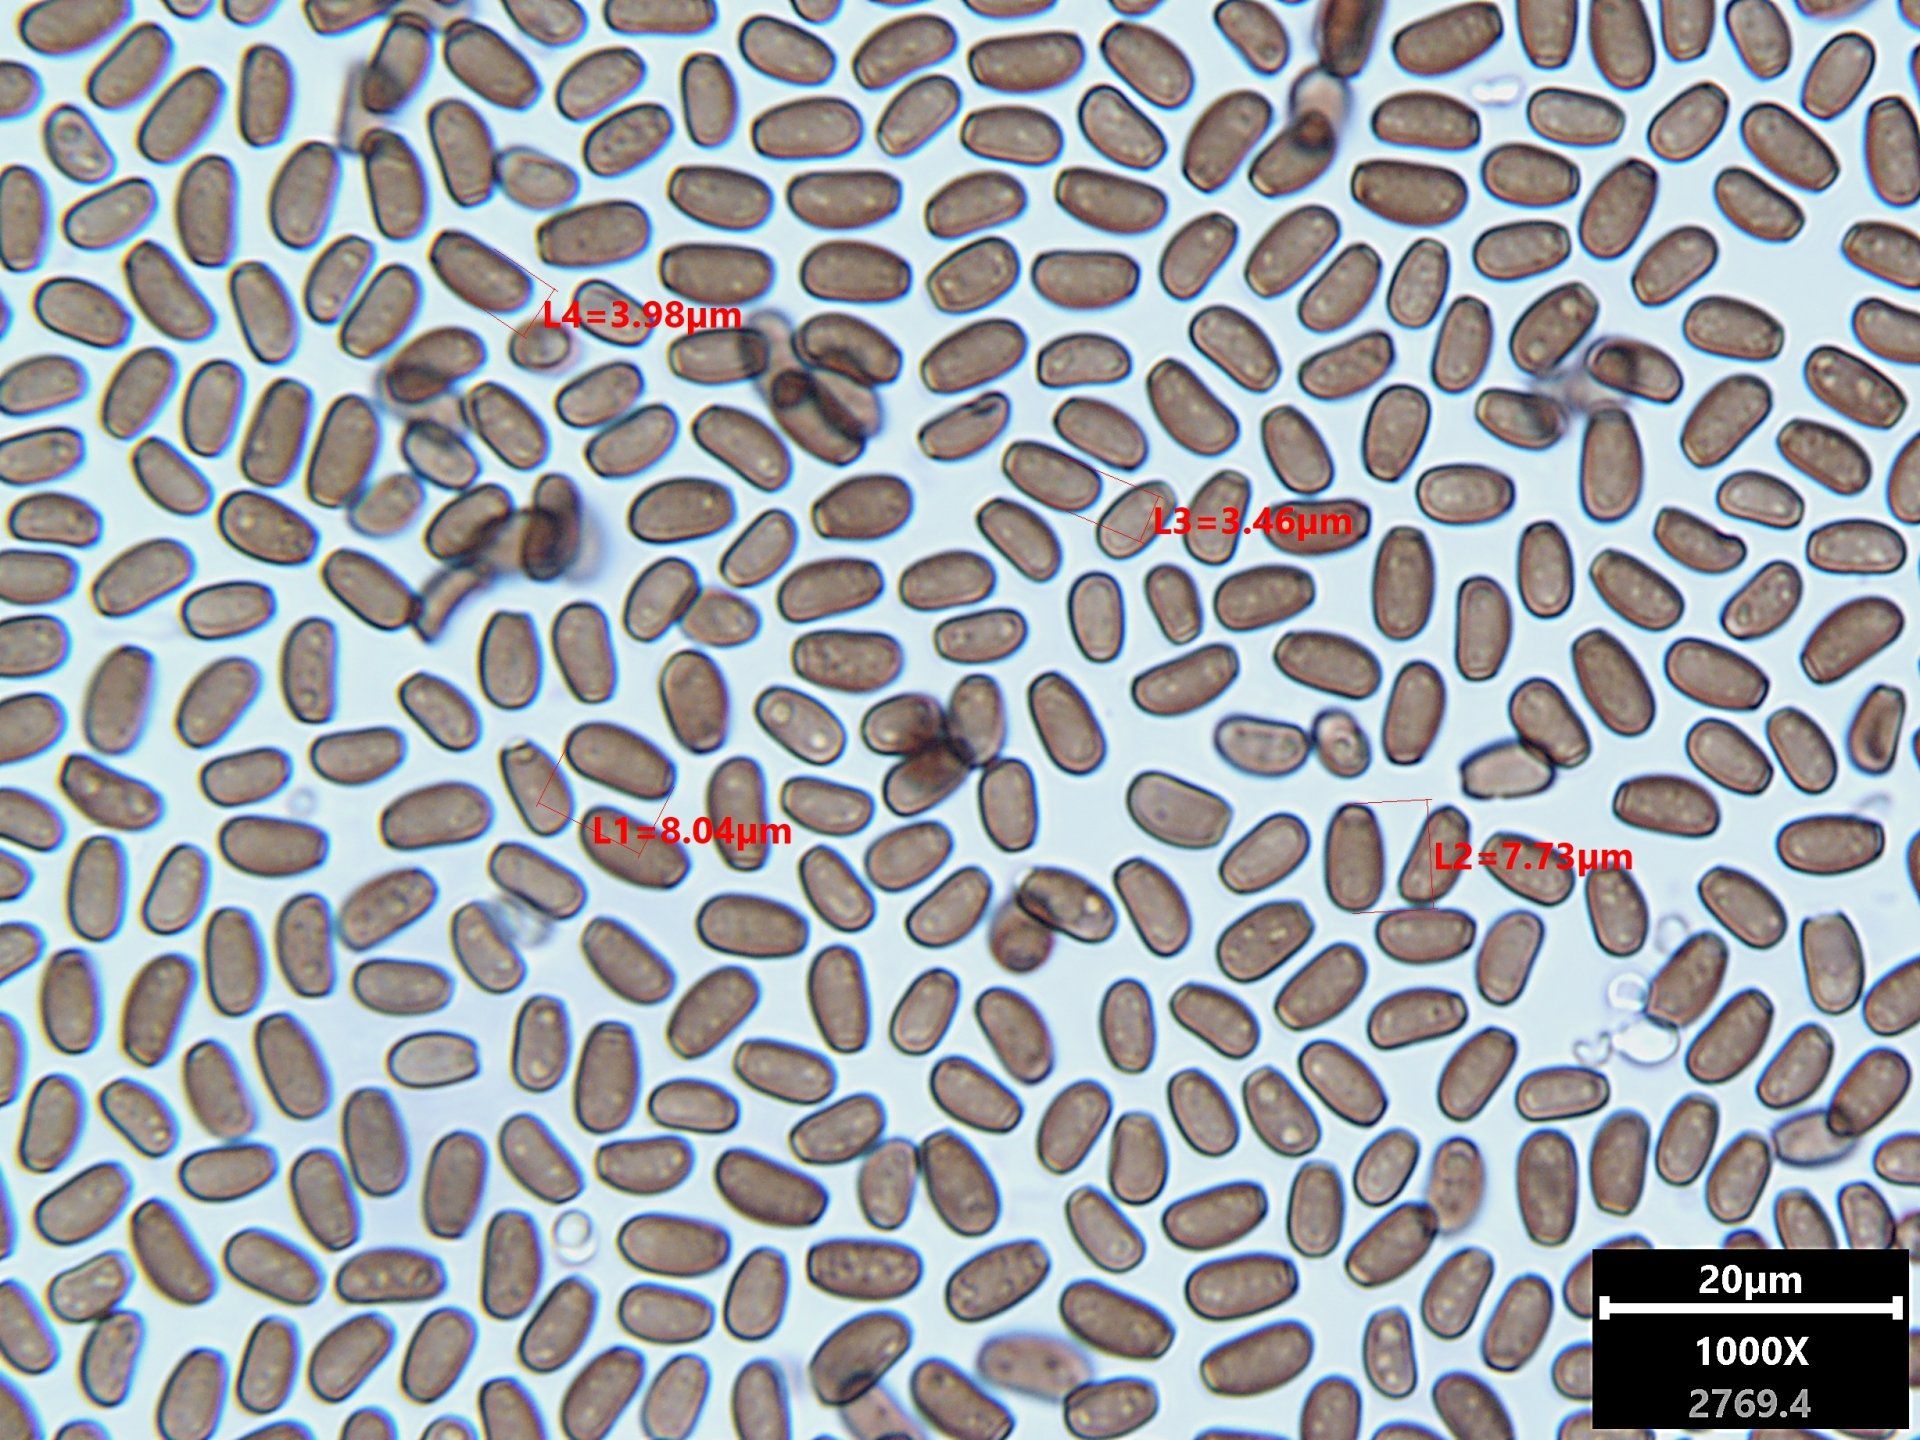

Les champignons saprotrophes
Ces champignons qui dégradent le bois de nos maisons
Champignons du bois
Il existe une multitude de champignons destructeurs du bois des maisons. Ces champignons saprotrophes (qui se nourrissent du bois) provoquent des dommages aux bois caractérisés en quatre catégories ;
- la pourriture cubique,(espèces qui se nourrissent de la cellulose)
- la pourriture fibreuse,(espèces qui dégradent la lignine)
- la pourriture molle (moisissures).
- la pourriture alvéolaire dont les conséquences économiques sont moins importantes.
En Europe, deux espèces de mérules sont présentes, Serpula lacrymans
et Serpula himantioïde
appelée également mérule sauvage que l'on trouve principalement en forêt ou sur des bois extérieurs, très rarement à l'intérieur des maisons.
La mérule, S.lacrymans
(Schum), appelée également mérule pleureuse, est certainement le champignon le plus redoutable. Il provoque la pourriture cubique du bois. Il est aussi le plus courant et représente alors près de 30% des identifications des échantillons confiés au laboratoire.
Pour autant, un bois atteint par un agent de pourriture cubique n'est pas la signature obligatoire d'une infestation de mérule.
Le laboratoire a distingué parmi les champignons basidiomycètes les plus courants provoquant :
La pourriture cubique
- 19
polypores et
11
corticiés
La pourriture fibreuse - 17 polypores et 26 corticiés
La pourriture molle - 12 mycètes
La pourriture alvéolaire - 5 agaricales
La pourriture fibreuse - 17 polypores et 26 corticiés
La pourriture molle - 12 mycètes
La pourriture alvéolaire - 5 agaricales
Il existe donc au moins 30 espèces courantes
responsables de la pourriture cubique,
dontSerpula lacrymans, la redoutable mérule pleureuse et Coniophora puteana,
non moins redoutable mais plus aisé et moins coûteux à traiter.
INFORMATION MERULE - Dossier très complet sur la mérule établi par l'agence pour l'habitat (ANAH)
SERPULA LACRYMANS
Sporophore de la mérule des maisons Serpula lacrymans qui s'étale au sol sous un meuble. Au moindre courant d'air, des milliards de spores prennent la voie des airs pour coloniser d'autres lieux humidesSERPULA LACRYMANS
Développement du redoutable champignon Serpula lacrymans, la mérule en sous-face de plancher de caveSERPULA LACRYMANS
Système hyphal dimitique de la mérule ; Hyphes génératrices distinctement bouclées, hyalines, 2-5 µm de diam.,(Serpula lacrymans)
Gross. x 1000
SERPULA LACRYMANS
Spores ovoïdes à ellipsoïdes, parfois guttulées, jaunes, (8)9(11)-12(14) x 4,5(5,5)-7(8) µm (Serpula lacrymans) MéruleGross. x 1000
SERPULA LACRYMANS
Hyphes squelettiques et spore de la mérule, hyphes squelettiques acyanophiles, 2,6 µm de diamGross. x 500 + rouge congo ammoniacal
SERPULA LACRYMANS
Système hyphal dimitique ; hyphes génératrices bouclées, à paroi mince, hyalines, 2-5 µm de diam., parfois à contenu foncé jusqu'à 8 µm de diam.; hyphes squelettiques acyanophiles, 2,6 µm de diamGross x 500 + rouge congo
CONIOPHORA PUTEANA
Système hyphal monomitique de Coniophora puteana
; hyphes génératrices subiculaires à paroi mince à épaisse, peu ramifiées, hyalines, parfois lâchement incrustées, 2-10 µm de diam., parfois fortement ampoulées jusqu'à 20 µm de diam. Gross.x 500CONIOPHORA PUTEANA
Spores ovoïdes à ellipsoïdes, lisses, à paroi épaissie, à contenu granuleux avec et petit appendice hilaire, brun jaunâtre pâle dans le KOH, devenant lentement dextrinoïde, 8-13(14) x 5-8(9) µm. Gross. x 1000
LEUCOGYROPHANA MOLLUSCA
Hyménophore fortement mérulioïde, orange brillant au frais, chamois à jaunâtre ocre au sec.Leucogyrophana mollusca
Gross. x 50
LEUCOGYROPHANA MOLLUSCA
Système hyphal monomitique ; hyphes génératrices bouclées, à paroi mince, noduleuses-septées, parfois ramifiées près des septa, hyalines, 3-6 µm de diam. Leucogyrophana Gross x 1000 + rouge congo
CHAETOMIUM ELATUM
ascospores de couleur brunâtres avec pore germinatif apical (9-12 µm × 8-10 µm × 6-8 µm) limoniformes vues de face et aplaties bilatéralement.Chaetomium elatum
Gross. x 500
ASTEROSTROMA LAXUM
Grandes astéhyphidies (soies étoilées) à parois épaisses contenant de 3 à 8 rayons de couleur brun-jaunâtreAsterostroma laxum
Gross. x 500